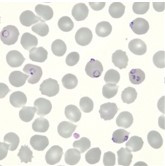

Our work focuses on elucidating the molecular interactions between host and parasite that underlie malaria pathology and the development of protective immunity. A major research direction is the generation of live, genetically attenuated parasites to create highly effective vaccines that can contribute to malaria eradication. In addition, the group is actively engaged in improving vaccine delivery and potency, as well as in defining the immunological mechanisms induced by attenuated parasites. As part of the Leiden vaccine research community (The Leiden Vaccine Group | Accelerate vaccine development), we are uniquely positioned to translate pre-clinical findings into clinical trials and to apply clinical insights to the further refinement of malaria vaccine strategies.
The Transgenic Parasites in Malaria research team closely collaborates with the Translational Parasitology group, led by Prof. Dr. M. Roestenberg, which focuses on the clinical translation of biological and epidemiological insights. We also work in partnership with the Molecular Immunology team of Dr. R. Murugan.